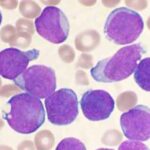

Uma pesquisa do Datafolha, divulgada neste sábado (7) pela Folha de S.Paulo, aponta que o presidente Luiz Inácio Lula da Silva (PT) e o senador Flávio Bolsonaro (PL) aparecem tecnicamente empatados em um cenário de segundo turno nas eleições presidenciais de 2026. No levantamento, Lula tem 46% das intenções de voto, enquanto Flávio registra 43%, dentro da margem de erro de dois pontos percentuais.
A pesquisa foi realizada entre os dias 3 e 5 de março, com 2.004 entrevistados em 137 municípios brasileiros. O nível de confiança é de 95%, com margem de erro de dois pontos percentuais, para mais ou para menos. O levantamento está registrado no Tribunal Superior Eleitoral (TSE) sob o número BR-03715/2026.
Pesquisa espontânea mostra Lula na liderança
Na pesquisa espontânea, quando os nomes dos candidatos não são apresentados aos entrevistados, Lula aparece na frente:
-
Luiz Inácio Lula da Silva (PT): 25%
-
Flávio Bolsonaro (PL): 12%
-
Jair Bolsonaro (PL): 3%
-
Votar no PT/candidato do PT: 1%
-
No atual presidente: 1%
-
Outras respostas: 5%
-
Nenhum/Branco/Nulo: 8%
-
Não vota: 1%
-
Não sabe: 44%
Jair Bolsonaro aparece na pesquisa espontânea, apesar de estar inelegível até 2030 após decisão do Tribunal Superior Eleitoral por abuso de poder político e uso indevido dos meios de comunicação.
Cenários estimulados de primeiro turno
O Datafolha também simulou cinco cenários de primeiro turno, com diferentes nomes na disputa.
Cenário com Eduardo Leite
-
Lula (PT): 39%
-
Flávio Bolsonaro (PL): 34%
-
Eduardo Leite (PSD): 3%
-
Romeu Zema (Novo): 4%
-
Renan Santos (Missão): 3%
-
Aldo Rebelo (DC): 2%
-
Nenhum/Branco/Nulo: 12%
-
Não sabe: 3%
Cenário com Ronaldo Caiado
-
Lula (PT): 39%
-
Flávio Bolsonaro (PL): 33%
-
Romeu Zema (Novo): 5%
-
Ronaldo Caiado (PSD): 4%
-
Renan Santos (Missão): 3%
-
Aldo Rebelo (DC): 2%
-
Nenhum/Branco/Nulo: 12%
-
Não sabe: 3%
Cenário com Ratinho Junior
-
Lula (PT): 38%
-
Flávio Bolsonaro (PL): 32%
-
Ratinho Junior (PSD): 7%
-
Romeu Zema (Novo): 4%
-
Renan Santos (Missão): 3%
-
Aldo Rebelo (DC): 2%
-
Nenhum/Branco/Nulo: 11%
-
Não sabe: 3%
Cenário com Tarcísio e Ratinho
-
Lula (PT): 39%
-
Tarcísio de Freitas (Republicanos): 21%
-
Ratinho Junior (PSD): 11%
-
Romeu Zema (Novo): 5%
-
Renan Santos (Missão): 3%
-
Aldo Rebelo (DC): 2%
-
Nenhum/Branco/Nulo: 15%
-
Não sabe: 4%
Cenário sem Lula
Em uma simulação sem Lula, com Fernando Haddad (PT) como candidato:
-
Flávio Bolsonaro (PL): 33%
-
Fernando Haddad (PT): 21%
-
Ratinho Junior (PSD): 11%
-
Romeu Zema (Novo): 5%
-
Renan Santos (Missão): 4%
-
Aldo Rebelo (DC): 2%
-
Nenhum/Branco/Nulo: 20%
-
Não sabe: 4%
Simulações de segundo turno
O instituto também testou sete cenários de segundo turno. Veja alguns resultados:
-
Lula (PT): 46% x Flávio Bolsonaro (PL): 43%
-
Lula (PT): 45% x Tarcísio de Freitas: 42%
-
Lula (PT): 45% x Ratinho Junior: 41%
-
Lula (PT): 46% x Ronaldo Caiado: 36%
-
Lula (PT): 46% x Eduardo Leite: 34%
-
Flávio Bolsonaro: 43% x Fernando Haddad: 41%
-
Ratinho Junior: 40% x Fernando Haddad: 40%
Rejeição dos candidatos
O Datafolha também mediu o índice de rejeição, perguntando em qual candidato o eleitor não votaria de jeito nenhum.
-
Lula (PT): 46%
-
Flávio Bolsonaro (PL): 45%
-
Fernando Haddad (PT): 27%
-
Ratinho Junior (PSD): 19%
-
Tarcísio de Freitas (Republicanos): 18%
-
Romeu Zema (Novo): 17%
-
Eduardo Leite (PSD): 15%
-
Renan Santos (Missão): 14%
-
Ronaldo Caiado (PSD): 14%
-
Aldo Rebelo (DC): 12%
Segundo o instituto, pesquisas eleitorais refletem apenas um retrato do momento político, podendo sofrer variações ao longo do tempo conforme o cenário eleitoral evolui.